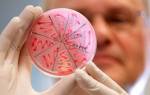

Грибковое заболевание, которое характеризуется поражением кожных покровов, слизистых оболочек и внутренних органов, называется системный микоз. Ему характерно длительное течение болезни и стойкость к применяемой терапии. Такой вид микоза проявляется шелушением и жжением кожи, появлением язв на слизистых и кожных покровах, болями в животе и сильным кашлем. Длительное протекание системного микоза приводит к опасным для жизни человека последствиям, поэтому очень важно его вовремя диагностировать и начать лечение.
Современные взгляды на этиологию и тактику лечения грибовидного микоза
Грибовидный микоз – это труднодиагностируемое и неуклонно прогрессирующее раковое заболевание, являющееся разновидностью Т-клеточных лимфом. Злокачественный процесс вызван бесконтрольным перерождением и делением Т-лимфоцитов в коже и лимфоузлах.
Причины появления
Выявлено более 25 разновидностей онкологических поражений лимфоидной ткани кожи. Среди всех лимфом наиболее распространены Т-клеточные, самой редкой из них является грибовидный микоз (МГ). В группе риска по данной патологии – лица старше 55 лет. Соотношение заболевающих женщин и мужчин – 2 к 1,6.
Этиология грибовидного микоза не известна. Согласно результатам ряда исследовательских работ, его развитие могут провоцировать ретровирусы. В первичных клеточных культурах, взятых у заболевших МГ, неоднократно выявлялись вирусные частицы, характерные по морфологическим данным для ретровирусов C типа. А в ДНК клеточных культур – генетические последовательности, родственные Т-лимфотропному вирусу 1 типа.
В ходе ряде других исследований была установлена взаимосвязь между отдельными группами заболевших МГ: на них воздействовали одинаковые негативные факторы, которые ускоряют воспроизведение лимфоцитов в коже и повышают риск образования мутантных клонов клеток. Среди них:
- затяжной хронический дерматоз;
- воздействие УФ-излучения;
- предрасположенность к раковым заболеваниям;
- влияние аллергенов и химических соединений.
Проявление поражения кожи грибовидным микозом


Опухолевая стадия заболевания сопровождается преобразованием бляшек в опухолевые очаги, достигающие размеров яблока. В течение нескольких последующих недель опухоли распадаются, образуя глубокие язвы с признаками некроза. Процесс сопровождается отсутствием аппетита, вялостью и быстрым снижением веса.
Все стадии грибовидного микоза сопровождаются увеличением лимфоузлов. Возможны периодические подъемы температуры до 39 °C, потливость, выпадение волос, отслаивание ногтей.
Проявления
Всего различают три стадии заболевания – эритематозная, бляшечная и опухолевая. Каждая из них обладает собственной симптоматикой, поэтому мы перечислим симптомы в зависимости от стадии заболевания.
- Эритематозная. Сперва начинают зудеть некоторые участки кожи, потом на них образуются пятна желто-розового или красно-синего цвета. Размер пятен в диаметре: от 1 миллиметра до 20 сантиметров. Со временем пятна начинают шелушиться и становятся влажными. Пятна могут появиться где угодно, но чаще всего они встречаются на животе, а также на руках и ногах в области локтей и колен. Врачи утверждают, что подобная клиническая картина очень схожа с такими болезнями, как парапсориаз, экзема и некоторые другие. Поэтому вполне возможно, что данная стадия развития болезни – это фактически дерматоз, который в силу определенных причин переходит в микоз.
- Бляшечная. Для этой стадии характерна трансформация пятен – они становятся крупными и выходят за пределы кожи, фактически превращаясь в бляшки. Бляшки начинают расти, а их цвет становится красным; бляшки могут сливаться друг с другом. Также усиливается зуд. Иногда через некоторое время бляшки становятся мягкими и частично облущиваются, но периферийный рост бляшек не прекращается, в результате образуется зудящее кольцо с твердыми краями. Переход болезни от эритематозной стадии к бляшечной длится от нескольких месяцев до нескольких десятков лет.
- Опухолевая. На данной стадии кольцевидные бляшки трансформируются в полноценные кожные опухоли. Их размер может достигать более 20 сантиметров в диаметре, а их цвет становится сине-красным либо желто-красным. Некоторые бляшки распадаются и образуются глубокие язвы, которые покрыты погибшими тканями и кровяно-водянистыми выделениями. Опухоли могут давать метастазы во внутренние органы, вызывая обширные нарушения. В большинстве случаев у больного также снижается аппетит и появляется недомогание.
В некоторых случаях поражаются слизистые оболочки в горле. Существует несколько подтипов грибовидного микоза:
- Подтип Видаля-Брока. Основные отличия – отсутствует первая и вторая стадии, а опухолевые поражения чаще появляются на коже лица и конечностей.
- Подтип Галлопо-Бенье. Основные отличия – вся кожа покрывается красными и красно-бурыми пятнами, очень сильно повышается температура, что приводит к обезвоживанию.
На всех стадиях кожного грибовидного микоза наблюдается увеличение лимфатических узлов и повышение температуры, а также появляются повышенная потливость ночью.
Как определить первые симптомы
Из-за внешнего вида высыпаний синдром Алибера-Базена в эритематозно-сквамозной стадии часто путают с псориазом, экземой, дерматитом Дюринга. Лабораторная диагностика заболевания также затруднена в связи с отсутствием изменений в морфологии крови.
Осложняет ситуацию и тот факт, что многие врачи недостаточно ознакомлены с клиникой грибовидного микоза.
Больной может самостоятельно заподозрить синдром Алибера-Базена по мучительному кожному зуду, увеличению лимфоузлов, особенно паховых, утолщению эпидермиса на ладонях и подошвах. При появлении подобных симптомов следует обратиться к дерматологу для проведения иммуногистохимического исследования биоматериала, взятого при биопсии. Это единственный эффективный способ диагностики данной разновидности Т-клеточной лимфомы.
Лечение народными средствами
Синдром Алибера-Базена не лечится народными средствами. Их применение допустимо только на ранних стадиях заболевания и лишь в сочетании с консервативной терапией. Применяются следующие лечебные составы:
- Марганцовка (1 г) + соль (2 ст. л.). Ингредиенты помещают в таз с водой и перемешивают до полного растворения. Готовый раствор используется в качестве ванночки для ног.
- Листья лопуха (1 ст. л.) + листья подорожника (1 ст. л.). Ингредиенты погружают в кипяток и отставляют на сутки. Отвар принимают внутрь. Разовая доза – 150 мл.
- Цветы сирени + спирт (1:2). Растение настаивают на спирту в темном месте на протяжении недели. Настойка используется для местной обработки кожи дважды в сутки.
Профилактика

Прогноз при синдроме Алибера-Базена неблагоприятный. Заболевание может прогрессировать на протяжение 2–13 лет. Если оно выявлено на опухолевой стадии, лечение будет неэффективным – больного ожидает летальный исход. При раннем диагностировании ГМ возможно значительное замедление злокачественного процесса или полное исцеление. Поэтому следует внимательно следить за состоянием кожного покрова.
Что такое грибовидный микоз?
Грибовидный микоз относится к Т-клеточным лимфомам. Это злокачественное заболевание, поражающее кожу. При прогрессировании, грибовидный микоз переходит на лимфатическую систему и может поражать внутренние органы.
Грибовидный микоз относится к лимфомам с низкой степенью злокачественности. Несмотря на всю опасность заболевания, оно развивается медленно. Основный риск при грибовидном микозе кожи – это поражение лимфатических узлов. Тем не менее этому процессу предшествует долгий период развития болезни на эпидермисе. Тяжелые осложнения и прогрессирующее поражение внутренних органов – это последняя стадия болезни.
В патологический процесс вовлекается лимфоидная ткань. Для такого типа лимфомы характерно избыточное разрастание клеток, что и формирует клиническую картину или симптомы грибовидного микоза.
Несколько фактов о заболевании:
- одинаково часто встречается и у женщин, и у мужчин;
- средний возраст пациентов – старше 40 лет;
- точная причина развития болезни неизвестна;
- течение заболевания может растянуться на 5-15 лет.
Грибовидный микоз по МКБ-10 обозначается как C84.0. В международной классификации болезней МКБ-10 грибовидный микоз относится к подгруппе Т-клеточных лимфом.
Как развивается болезнь?
Врачи-дерматологи считают, что главной причиной заболевания является опухолевое злокачественное поражение лимфоидной кожной системы. Грибковый микоз относят к типу лимфом, что поражают кроветворную и лимфатическую ткани. На начальном этапе развития грибовидного микоза обнаруживается воспаленное скопление в кожной ткани клеточных элементов с примесями крови и лимфы. Иногда в таком уплотнении обнаруживается небольшое накопление ретикулярных клеток.
При обследовании больного часто обнаруживается, что внутренние органы поражены узловидными уплотнениями, идентичными тем, что на коже. При опухолевой (последней) стадии микозные клетки и инфильтрат поражают жировую подкожную клетчатку. Грибовидным микозом может быть поражен костный мозг, если болезнь сильно запущена. Прогноз случаев поражения внутренних органов и костного мозга крайне неблагоприятен.
Причины развития и факторы риска
Точные причины развития грибовидного микоза до сих пор остаются под вопросом. Существует множество теорий, от генетической до инфекционной природы заболевания, однако ни одна из них не получила подтверждения. Грибовидный микоз характеризуется неконтролируемой Т-клеточной пролиферацией, то есть в какой-то момент в организме начинается процесс активного разрастания клеток. Заболевание относится к онкологическим, но точная причина и механизм развития этой формы лимфомы неизвестны.
Среди возможных причин рассматривается вирусная природа развития этого заболевания. Это обусловлено тем, что у больных грибовидным микозом были выявлены специфические изменения в лимфатических узлах, которые похожи на последствия активности ретровирусов типа С.
В пользу генетической теории происхождения этого заболевания свидетельствует особая последовательность генов, определяемая у пациентов с данным заболеванием. Последовательность во многом напоминает так называемый ген рака, но не является им в полной мере, что оставляет еще больше вопросов о природе заболевания.
Хромосомные аномалии могут выступать косвенной причиной развития любых форм рака, включая злокачественную лимфому. При грибовидных микозах наблюдаются специфические хромосомные аномалии и перестройки хромосом, которые можно было бы связать с пролиферацией Т-клеток. В то же время, такие аномалии выявляются и у совершенно здоровых людей.
Аутоиммунная теория развития грибовидного микоза множество раз подвергалась критике, но так и не была опровергнута, впрочем, как и доказана. Существует мнение о том, что аутоиммунные нарушения, провоцирующие пролиферацию Т-лимфоцитов в организме, могут иметь генетическую природу наследования.
Таким образом, точные причины развития неизвестны, поэтому грибовидный микоз с одинаковой вероятностью может быть вызван:
- наличием особого гена или хромосомных аномалий;
- аутоиммунными нарушениями;
- изменениями в работе иммунитета;
- ретровирусами.
К факторам риска можно отнести возраст пациента. Грибовидный микоз встречается только у людей старше 40 лет, независимо от пола и места проживания. Частота встречаемости заболевания не зависит от климатических условий и цвета кожи.
Болезнь поражает людей среднего возраста любой расы и страны
Стадии и симптомы
Грибовидный микоз кожи на фото выглядит схожим с симптомами грибковых дерматомикозов. Патология внешне напоминает крупные пятна бляшечного типа, возвышающиеся над кожей. При этом пораженные участки краснеют, появляется шелушение. Такая симптоматика не позволяет быстро диагностировать кожный рак, поэтому грибовидный микоз кожи может длительное время лечиться неправильно.
Различают три формы болезни – классическая лимфома Алибера-Базена, эритродермический микоз Аллопо-Бенье, лейкемическая форма (синдром Сезари). В подавляющем большинстве случаев речь идет о классической форме заболевания.
Классический грибовидный микоз развивается медленно и проходит в три этапа. Стадии заболевания:
Эритематозная стадия – это самое начало патологического процесса. При этом на коже появляется красная сыпь, которая ошибочно принимается за дерматоз или микоз кожи. Сыпь распространяется пятнами и окрашена в яркий цвет, размеры каждого пятна варьируются от 2 до 200 мм в диаметре. Кожа вокруг высыпаний отекает, появляется сильный зуд. Спустя несколько недель образуется мокнущая сыпь, кожа вокруг нее становится сухой и шелушится. Пятна могут появляться на любых участках тела, но чаще всего болезнь поражает спину, шею, живот, ноги и руки. Нередко первичные симптомы появляются на коленях и внутренней части локтя.
Вторая стадия развития заболевания характеризуется образованием бляшек. Кожа в месте высыпаний меняется, становится более плотной, возвышается над здоровым эпидермисом. Бляшки сильно гиперемированы, по контуру появляется шелушение. Это сопровождается сильным зудом и дискомфортом.
На опухолевой стадии бляшки меняются, на их месте появляются кожные новообразования или наросты. Размеры каждой опухоли могут достигать 20-25 см. На теле пациента может присутствовать сразу несколько таких опухолей. При повреждении новообразований появляются эрозии, которые не заживают. Нередко на месте повреждения начинается некроз тканей. На этой стадии лимфома поражает лимфатическую систему, появляются метастазы. Грибовидный микоз метастазирует во внутренние органы, реже – в костную ткань.
Опухолевая стадия болезни
Самая длительная стадия заболевания – это эритематозная. Сыпь на коже может сохраняться в течение долгих лет. Известны случаи, когда эритематозная форма перетекала в бляшечную за два десятка лет. Длительность бляшечной стадии заболевания значительно короче – не больше 2-3 лет. Затем болезнь продолжает прогрессировать и на коже появляются опухоли. Точно предсказать, как скоро лимфома начнет поражать лимфатические узлы, невозможно.
На каждом этапе грибовидного микоза наблюдаются симптомы, характерные для злокачественных процессов, скрытно протекающих в организме:
- быстрая утомляемость;
- апатия;
- постоянная сонливость;
- снижение аппетита.
На поздних стадиях появляются симптомы интоксикации, может повышаться температура тела. Начиная с бляшечной стадии заболевания, у пациента заметно увеличиваются лимфатические узлы.
Разновидности микоза кожи
Микоз – это большая группа болезней. Различные подвиды патологии различаются по локализации и степени поражения. Существует две основные группы. Глубокие микозы – оппортунистические и подкожные, споротрихоз, хромобластомикоз. Поверхностные – кандидоз, дерматомикоз и кератомикоз.
- кератомикозы. Из этой группы чаще всего встречается лишай разноцветный, для которого характерным является появлением пятен по телу, лицу, которые, по мере прогрессирования патологического процесса, начинают шелушиться;
- дерматомикозы. Эта группа объединяет несколько видов кожных болезней. О появлении дерматомикоза говорят в том случае, если на теле появляются характерные красные пятна, воспаляются кожные покровы, происходит их активное шелушение;
- кандидозы – это заболевания, вызванные дрожжевыми грибками. Недуги такого типа распространяются по тканям всех органов и частей тела, за исключением волос. Инфекция чаще всего развивается в складках кожи. Наиболее опасные места – в подмышечной впадине, в межпальцевых пространствах;
- гистоплазмоз, хромомикоз, криптококкоз и др. Эта группа инфекционных заболеваний характеризуется заражением глубоких слоёв кожи, а поэтому они являются наиболее опасными и тяжёлыми, но встречаются довольно редко. В этом случае необходимо своевременно и тщательно провести диагностику и назначить адекватное лечение. Как правило, лечить данные патологии очень сложно.
Микоз кожи бывает острым и хроническим, глубоким и поверхностным, очаговым и распространённым.
Диагностика
Грибовидный микоз – это редкий диагноз, который требует дифференциальной диагностики с другими кожными заболеваниями. Это обусловлено симптомами общего характера, которые характерны для микозов, дерматозов, некоторых форм псориаза и экземы.
На начальной стадии заболевание диагностируется сложнее всего. Обычно ставится диагноз «дерматоз» и пациента начинают лечить различными кремами и мазями. Такое лечение не приносит результата, поэтому проводятся дополнительные обследования – соскоб кожи, бактериальный посев слизистой оболочки. Эти анализы проводят с целью выявления грибков.
Виды микоза
Разновидность заболевания определяется областью поражения, а также глубиной прорастания грибка. На данный момент выделяют такие заболевания, как:
- кератомикоз;
- дерматофития;
- руброфития;
- микроспория;
- фавус;
- паховая эпидермофития;
- кандидоз.
Каждый из недугов имеет характерные симптомы.
Принцип лечения
Еще интересней:
Эффективные уколы от простатита
Является ли дюфастон гормональным средством
Даже при раннем диагностировании лечение направлено скорее на сдерживание болезни
Лечить грибовидный микоз предлагается следующими средствами:
- противоопухолевые антибиотики;
- цитостатики;
- кортикостероиды.
Цитостатики сдерживают процесс пролиферации Т-клеток. Их назначают при прогрессировании заболевания. Применение этих лекарств на начальной стадии грибовидного микоза позволяет добиться устойчивой ремиссии. Эти препараты составляют основное направление в лечении злокачественного заболевания.
Кортикостероиды сдерживают увеличение участков поражения и не позволяют им распространиться на здоровую кожу. Также эти препараты уменьшают зуд и дискомфорт. Они применяются в форме мазей и кремов и наносятся на пораженные участки в соответствии с особой схемой лечения, подобранной врачом.
Дополнительно могут применяться препараты для уменьшения симптомов заболевания, включая лекарства от зуда. Хороший результат достигается путем применения фототерапии и рентгенотерапии.
Диагностика и лечение
Микологи и дерматологи занимаются лечением грибковой инфекции. Они назначают необходимые анализы для диагностики – лабораторные исследования, материалом для которого служат разные субстраты. Например, кровь, волосы, мокроты, кусочек ногтя, чешуйки с места поражения и пр.
Полученные биологические материалы в лабораторных условиях обрабатываются специальными реактивами, проводится микроскопическое исследование. Чтобы определить разновидность грибка, используют культуральные способы диагностики. Для этого осемененный материал помещается в благоприятную среду.
Для выявления некоторых разновидностей дерматомикозов используют лампу Вуда. Параллельно доктор пытается установить первоисточник проблемы – надо сдать анализ на ВИЧ, глюкозу, венерические болезни и пр.
Современная медицинская практика имеет в арсенале много эффективных препаратов, ориентированных на избавление от грибковой инфекции. Это системные лекарства (таблетки) и местные средства (мази, растворы, кремы, гели, лаки, спреи). Лечебный курс определяется индивидуально в зависимости от индивидуальных особенностей пациента и таких факторов:
- Длительность заболевания по времени.
- Величина пораженной площади кожи.
- Наличие сопутствующих недугов.
- Выраженность клиники и пр.
Современные противогрибковые медикаменты быстро и эффективно тормозят прогрессирование заболевания, разрушают грибковые микроорганизмы. Препараты имеют свойства скапливаться в ногтях и тканях, что обеспечивает требуемый терапевтический результат даже вне применения.
Применение лазера
Медикаментозное лечение ногтей длится долго, в запущенных случаях не помогает. Поэтому используют лазерную терапию. Она отличается безболезненностью, малым реабилитационным периодом, небольшим списком противопоказаний, хорошими отзывами.
Суть манипуляции в том, что доктор направляет излучение лазера вглубь ногтя, нагревает грибковые споры. Продолжительность лечебного воздействия зависит от лазерного аппарата, применяемого для терапии. Промежуток между манипуляциями 7-30 дней. Для полного излечения понадобится 3-10 процедур.
Улучшения можно наблюдать уже после первой манипуляции. Но терапия продолжается до тех пор, пока ногтевая пластина полностью не сойдет.
Противогрибковые лаки
Если отсутствует сильная деформация ногтевой пластины, нет осложнений, то используют антимикотические лаки. Действуют эффективно, но минусом является стоимость.
Хорошие лаки от грибка:
- Микозан.
- Батрафен.
- Лоцерил.
- Офломил.
Важное дополнение: Почему синеет ноготь на большом пальце ноги?
Лаки надо использовать при онихомикозе 6-12 месяцев. Наносят на пораженный ноготь 1-2 раза в неделю. Перед нанесением требуется подготовка – делают горячую ванночку. Лак создает защитную пленку на ногте, предупреждает развитие и размножение грибков.
Все лаки обладают фунгистатическим и фунгицидным эффектами.
Кератолитики
Ногтевую пластину можно удалить хирургическим путем, но это больно, реабилитационный период длительный, есть риск рецидива. В качестве альтернативы используют специализированные медикаменты для безболезненного удаления ногтя – их называют кератолитики.
Например, средство Ногтивит. Практически нет противопоказаний, к побочным действиям приводит редко, стоимость около 150 рублей. Для покупки рецепт врача не нужен. В составе масло чайного дерева, стеариновая кислота и мочевина. Эти вещества помогают избавиться от больного ногтя, предупреждают распространение инфекции на здоровые пластины.
Перед нанесением Ногтивита надо распарить пластину. В 2 литра воды добавляют 2 столовых ложки гидрокарбоната натрия и такое же количество жидкого мыла. Время процедура – 20 минут, после ногти высушить. Здоровую кожу вокруг пластины обезопасить пластырем.
Нанести Ногтивит на ноготь, сверху зафиксировать лейкопластырем. Оставить на 3-4 дня. Снять, сделать ванночку, убрать размягченный слой. Снова повторить манипуляцию. И так до полного излечения. Аналогом Ногтивита является Ногтимицин.
Противогрибковые таблетки
Когда заболевание быстро прогрессирует, поражено больше 60% ногтя либо несколько ногтевых пластин, без таблеток не обойтись. Сочетают капсулы и средства местного действия. К хорошим мазям относят Микозолон, Ламизил и Экзодерил.
Название таблеток и стоимость:
- Флуконазол. В составе действующее вещество флуконазол. Стоит около 80 рублей.
- Орунгал – дорогой препарат, в составе итраконазол. Цена около 2500 рублей. Дешевые аналоги – Кандитрал (400 рублей) и Ирунин (около 300 руб.).
- Ламизил – в составе тербинафин. Цена около 1700 рублей. Наиболее дешевый аналог Экзифин.
Лечение онихомикоза таблетками длится до отрастания нового ногтя и полного исчезновения симптоматики. Но чтобы убедиться в эффективности проведенного лечения, требуется сдать анализы.
Материал сдают на 14 и 30 сутки после завершения терапии.
Прогноз
Грибовидный микоз – это редкое заболевание, которое сложно диагностируется и почти не лечится. Патология прогрессирует медленно и характеризуется смазанной симптоматикой, которая часто становится причиной неадекватной терапии.
Прогноз, как правило, неблагоприятный. При своевременной диагностике и правильном лечении удается добиться устойчивой ремиссии на длительный срок и предотвратить развитие метастазирования. В этом случае длительность жизни с грибовидным микозом в среднем может достигать 12-15 лет.
В случае, когда патология выявлена на стадии образования опухолей, вылечить или хотя бы улучшить самочувствие пациента с помощью медикаментозной терапии невозможно. Лечение цитостатиками, облучение и другие методы терапии неэффективны, тяжелая форма болезни заканчивается летально. На третьей стадии развития болезни прогноз зависит от наличия метастазов. При поражении лимфатических узлов и внутренних органов смерть наступает спустя 6-18 месяцев.
Под диагнозом грибовидный микоз подразумевается онкологическое заболевание, которое поражает кожный покров. Патология не имеет никакого отношения к грибковым инфекциям. Хотя пациенты, услышав о ней, обычно думают иначе. Грибовидным микозом болезнь называют лишь потому, что она имеет похожие симптомы с дерматомикозом.
Трихофития и ее симптомы
Трихофития – это микоз, симптомы которого зависят от формы недуга. Это заразная инфекция, которая возникает в результате активной жизнедеятельности определенного грибка. На данный момент выделяют несколько форм:
- Антропофильная. В данном случае поражается гладкая кожа либо волосы на голове. Высыпания при этом недуге розовые, пятнисто-чешуйчатые. В местах очага волосы ломаются на высоте всего в несколько сантиметров. В результате этого создается впечатление возникновения черных точек.
- Антропонозная. Эта форма заболевания способна поразить не только человека, но и животных. Высыпания в этом случае ярко-розовые, крупные. Они шелушатся, а на их краях возникают корочки и фурункулы. При их вскрытии начинает вытекать гной. После терапии на кожных покровах образуются рубцы.
- Геофильная. Человек заболевает при контакте с зараженной почвой и поврежденными участками кожи. При этом развивается острый воспалительный процесс. Гибнет такой грибок при воздействии на него солнечных лучей.
Грибовидный микоз – что это
Злокачественное опухолевое поражение кожи
Грибовидный микоз, для которого выделен собственный код в МКБ 10, считается достаточно редким патологическим состоянием. Чаще всего от него страдают пациенты, которым около 40-60 лет. Больше заболеванию подвержены мужчины, чем женщины. Эту информацию подтверждает приведенная медиками статистика.
Болезнь развивается по причине размножения и перерождения Т-лимфоцитов. Специалистам не удалось выявить точные факторы, которые приводят к началу данного процесса. Заболевание является малоизученным. Медики до сих пор пытаются создать лекарственные средства, которые могут повысить шансы пациентов на выздоровление после заражения грибовидным микозом.
Содержание
Грибовидный микоз — редко встречающаяся разновидность Т-клеточной лимфомы эпидермиса, болезнь проявляется в одном случае из 345000. В большей части случаев (70-80%) болеют лица от 40 до 60 лет. У лиц мужского пола болезнь проявляется немного более часто, нежели у лиц женского пола. Главную роль в образовании грибовидного микоза выполняет размножение и злокачественная метаморфоза Т-лимфоцитов (обеспечивают реакции клеточного и гуморального иммунитета). Точные причины, которые запускают данный процесс, на сегодняшний день не известны. Существует предположение, что некоторую роль выполняют наследственные факторы и хроническая стимуляция процессов пролиферации и дифференцировки клеток лимфоидной системы при попадании в организм какого-либо антигена при постепенно нарастающем вирусном заболевании (герпетическая инфекция, вирус папилломы человека и другие)
Причины и факторы риска
Как уже говорилось ранее, медики не называют точные причины развития грибовидного микоза кожного покрова. Они лишь выдвигают теории, которые поверхностно объясняют появление патологии у того или иного человека. Ни одна из них пока не получила гарантированного подтверждения.
Патология, которая относится к числу болезней, вмещенных в перечень медицинской международной классификации, разрушает ткани эпидермиса. Это происходит по причине пролиферации Т-клеток. Болезнь принято считать онкологической, хоть и не понятно, почему внезапно начинает развиваться лимфома.
Рассматривается также генетическая теория развития грибовидного микоза. Все потому, что была обнаружена особая последовательность генов у пациентов с таким диагнозом.
К числу причин развития злокачественного заболевания относятся хромосомные аномалии. Они способны вызвать любой из существующих видов рака.
Неоднократно специалистами обсуждалась аутоиммунная теория развития грибовидного микоза. Ни доказать ее, ни опровергнуть так и не удалось.
Специалисты называют факторы риска, которые повышают вероятность развития болезни у конкретного человека. К ним относятся возраст старше 40 лет. Медикам не удалось увидеть зависимость появления патологии от пола, места проживания, цвета кожи и климатических условий.
Стадии и симптомы
Онкологическая патология проходит несколько стадий, и крайне важно начать лечение на раннем этапе
Грибовидный микоз, которым поражаются разные участки кожи, имеет несколько стадий развития. Больше всего шансов на выздоровление у тех пациентов, которые смогли своевременно обратиться к специалисту и начать лечение на раннем этапе болезни.
Каждая из стадий онкологической патологии характеризуется своими симптомами.
Эритематозная стадия
У больных начинает возникать зуд кожного покрова. После этого проявляются характерные для ракового заболевания пятна в наиболее незащищенном месте на теле человека. Стоит обратить внимание на тот факт, что зуд является одним из главных признаков микоза. Но у некоторых пациентов он отсутствует.
Развитие болезни на этом этапе выдают симптомы, характерные не только для грибовидного микоза, но и таких патологий, как экзема, лишай, парапсориаз и герпетиформный дерматит. Поэтому без профессиональной помощи человек не сможет отличить имеющееся у него нарушение, из-за которого страдает кожа.
По завершению течения эритематозной стадии заболевание переходит на новый этап своего развития. Данный процесс обычно занимает немало времени. Его продолжительность зависит от ряда факторов, к числу которых относится состояние больного, наличие воздействия на организм негативных факторов и форма онкологического заболевания. В среднем переход длится от пары месяцев до десятилетий.
Бляшечная стадия
Симптомы приобретают более плотную текстуру
При переходе в бляшечную стадию возникает инфильтрация пятен. Они приобретают более плотную текстуру. Также отмечается поднятие их контуров над поверхностью кожи. Именно так пятнышки превращаются в бляшки. Очень важно незамедлительно приступить к их лечению. В противном случае данные новообразования начнут увеличиваться в размере. Они изменять свой цвет на более багровый или кирпичный. Также на поверхности бляшек образуются бугорки. Еще одним симптомом этой стадии является появление невыносимого зуда, с которым невозможно справиться.
Почему развивается системный микоз
Системный микоз – общее название группы заболеваний, которые вызываются болезнетворными грибками. Они характеризуются поражением не отдельных органов, а всего организма. При развитии системного (глубокого) микоза инфекция локализуется в органах таких систем:
- опорно-двигательная;
- ЖКТ;
- нервная;
- кроветворная;
- сердечно-сосудистая.
Паразитические грибки проникают в слизистые оболочки, кожу и подкожную клетчатку. Болезнетворные микроорганизмы очень жизнеспособны, поэтому термин «системные» обозначает не степень поражения организма, а тяжесть инфекции. Без соответствующего лечения они приводят к несовместимым с жизнью осложнениям.
Некоторые грибковые заболевания, поражающие внутренние органы, отличаются высокой контагиозностью (заразностью). Их насчитывается более 10 видов, но многие микозы встречаются только в странах Азии, Америки и Африки. По клиническому течению и путям передачи инфекции они сильно отличаются от других патологий.
Длительное протекание системного микоза приводит к опасным для жизни человека последствиям, поэтому очень важно его вовремя диагностировать и начать лечение.
Системные болезни, поражающие кожу, слизистые оболочки и органы, могут вызываться инфекциями двух типов:
- Оппортунистические – провоцируются возбудителями, которые не представляют опасности для людей с нормальным иммунитетом. Грибок начинает активно размножаться на фоне снижения защитных сил организма.
- Эндемические – развиваются только при определенных условиях. К примеру, возбудитель кокцидиоидомикоза обитает в почве. Употребление воды с плесневым грибком приводит к отеку суставов, плевриту, лихорадке и смерти.
Микотическая флора живет на слизистых оболочках животных, поверхности почвы, в воде и т.д. Поэтому несоблюдение элементарных правил гигиены чревато проникновением инфекции в организм и развитием глубокого микоза.
К основным причинам заболевания относят:
- эндокринные нарушения;
- обострения хронических болезней;
- сахарный диабет;
- лечение цитостатиками, антибиотиками, иммунодепрессантами;
- ВИЧ-инфекцию;
- вторичные иммунодефициты;
- аутоиммунные нарушения;
- последствия химиотерапии;
- гормональные сбои;
- несоблюдение гигиены.
Степень агрессивности грибковых инфекций и возможные последствия системных заболеваний зависят от иммунного статуса человека. При сильном снижении реактивности организма болезнетворная флора развивается очень быстро, поражая жизненно важные органы.
Диагностика
Общий анализ крови позволяет выявить заболевание
Диагностическое исследование, проведенное в клинике, позволяет выявить данное заболевание. При таком диагнозе обязательно требуется прохождение ряда процедур, которые предусматривает дифференциальная диагностика.
При аномальном поражении кожи требуется в первую очередь отправиться на прием к дерматологу. Он должен провести осмотр пораженных участков эпителия и назначить больному определенные диагностические процедуры. Для постановки диагноза требуется прохождение следующих исследований:
- Общий анализ крови. Лабораторное исследование позволяет определить количество в образце лимфоцитов, эозинофилов и лейкоцитов. При грибовидном микозе эти показатели должны быть повышенными. Их понижение наблюдается лишь на последней стадии развития патологии;
- УЗИ и дерматоскопия. Диагностические мероприятия необходимы для выявления глубины поражения организма человека. Также они показывают текущее состояние внутренних органов, в которых мог начаться патологический процесс;
- Пункция на микобактерии. Анализ дает возможность выявить болезнь на раннем этапе ее развития. Даже на этой стадии в коже накапливается определенное количество жидкости, указывающее на изменение плотности эпителия и слизистых фибробластов.
Так же, как и при поражении грибками кожных покровов, могут потребоваться вспомогательные диагностические процедуры. Они необходимы для подтверждения правильности поставленного врачом диагноза.
Лечение
При подозрительных симптомах необходимо посетить дерматолога
Как именно устранить грибовидный микоз, должен решать специалист, которым назначается лечение больному с таким диагнозом. Медики предлагают традиционное лечение, которое основано на приеме лекарственных средств и прохождении процедур, облегающих состояние человека. Также пациенты пользуются народными методами, которые помогают справиться с болезненной симптоматикой онкологической патологии.
Традиционная терапия
Эффективность традиционного лечения болезни напрямую зависит от текущего состояния иммунитета пациента. Врачи предлагают больным начать прием медикаментозных препаратов, чтобы побороть патологию. Чтобы правильно определиться с выбором лекарств, пациент должен пройти осмотр не только у дерматолога, но также инфекциониста и онколога. Эти трое узкопрофильных специалиста должны составлять схему лечения для конкретного человека, который страдает от грибовидного микоза.
Пациент должен понимать, что лечить такое заболевание очень сложно. На проведение данной терапии потребуется потратить немало времени. При этом врачи не могут гарантировать больному выздоровление. Прогноз такого лечения зависит от множества факторов. Самым главным из них является состояние иммунной системы.
Терапевтический курс, которым проводят лечения грибовидного микоза кожного покрова, может включать в себя следующие медикаменты:
- Витаминные комплексы;
- Гормональные средства;
- Антибиотики широкого спектра действия;
- Кремы для наружной обработки кожи;
- Стероидные мази;
- Химические препараты;
- Средства с мышьяком.
При тяжелом течении болезни используются медикаменты с цитостатическим эффектом, а также средства с противоопухолевым действием.
Народные методы
Народные методы могут выступать только дополнением к медикаментозной терапии
Имеет смысл использовать народные методы лечения грибовидного микоза только на ранней стадии развития болезни. Но они даже в этом случае не смогут заменить традиционную терапию. Домашние средства пригодны для использования только в качестве дополнения. Этот момент обязательно нужно обсуждать со своим лечащим врачом.
Народная медицина рекомендует бороться с заболеванием такими средствами:
- Смесь из уксуса, куриного яйца и сливочного масла. Эти компоненты требуется перемешать и на 10 суток поставить в холодильник. После полученную массу нужно принимать по небольшой порции ежедневно.
- Соль и марганцовка. Их используют для приготовления лечебных ванночек, которые необходимо периодически принимать. Процедура должна проводиться в теплой воде.
- Настой из подорожника, лопуха и полыни. Листья лекарственных растений требуется залить водой и оставить на целую ночь. После лекарство пригодно для внутреннего приема.
- Винный уксус. Его рекомендуют добавлять в лечебные ванночки.
- Настойка прополиса. Она предназначена для протирания поврежденных участков на кожном покрове.
- Лук репчатый. Кашицу, сделанную из овоща, необходимо прикладывать в виде компрессов к пораженным зонам.
Не нужно забывать, что нетрадиционные методы могут лишь немного облегчить симптоматику, но не вылечить человека от самой болезни.
Профилактика микозов
Чтобы собственное тело всегда радовало своей внешней красотой и здоровьем, врачи рекомендуют своевременно проводить профилактические мероприятия в домашней обстановке. Общие рекомендации лечащего врача представлены ниже:
- носка исключительно личной одежды;
- мытье рук после контакта с животными (даже с домашними);
- использование собственных средств личной гигиены;
- ограничение общения с инфицированными микозом пациентами;
- качественная интимная гигиена паховых зон, складок на теле;
- укрепление ослабленного иммунитета.
Прогноз
При развитии грибовидного микоза прогноз неутешительный. Об этом медики говорят каждому пациенту с таким диагнозом. Особенно не стоит надеяться на выздоровление людям, которые начали лечить патологию на поздней стадии ее развития, когда наблюдаются необратимые разрушения тканей внутренних органов.